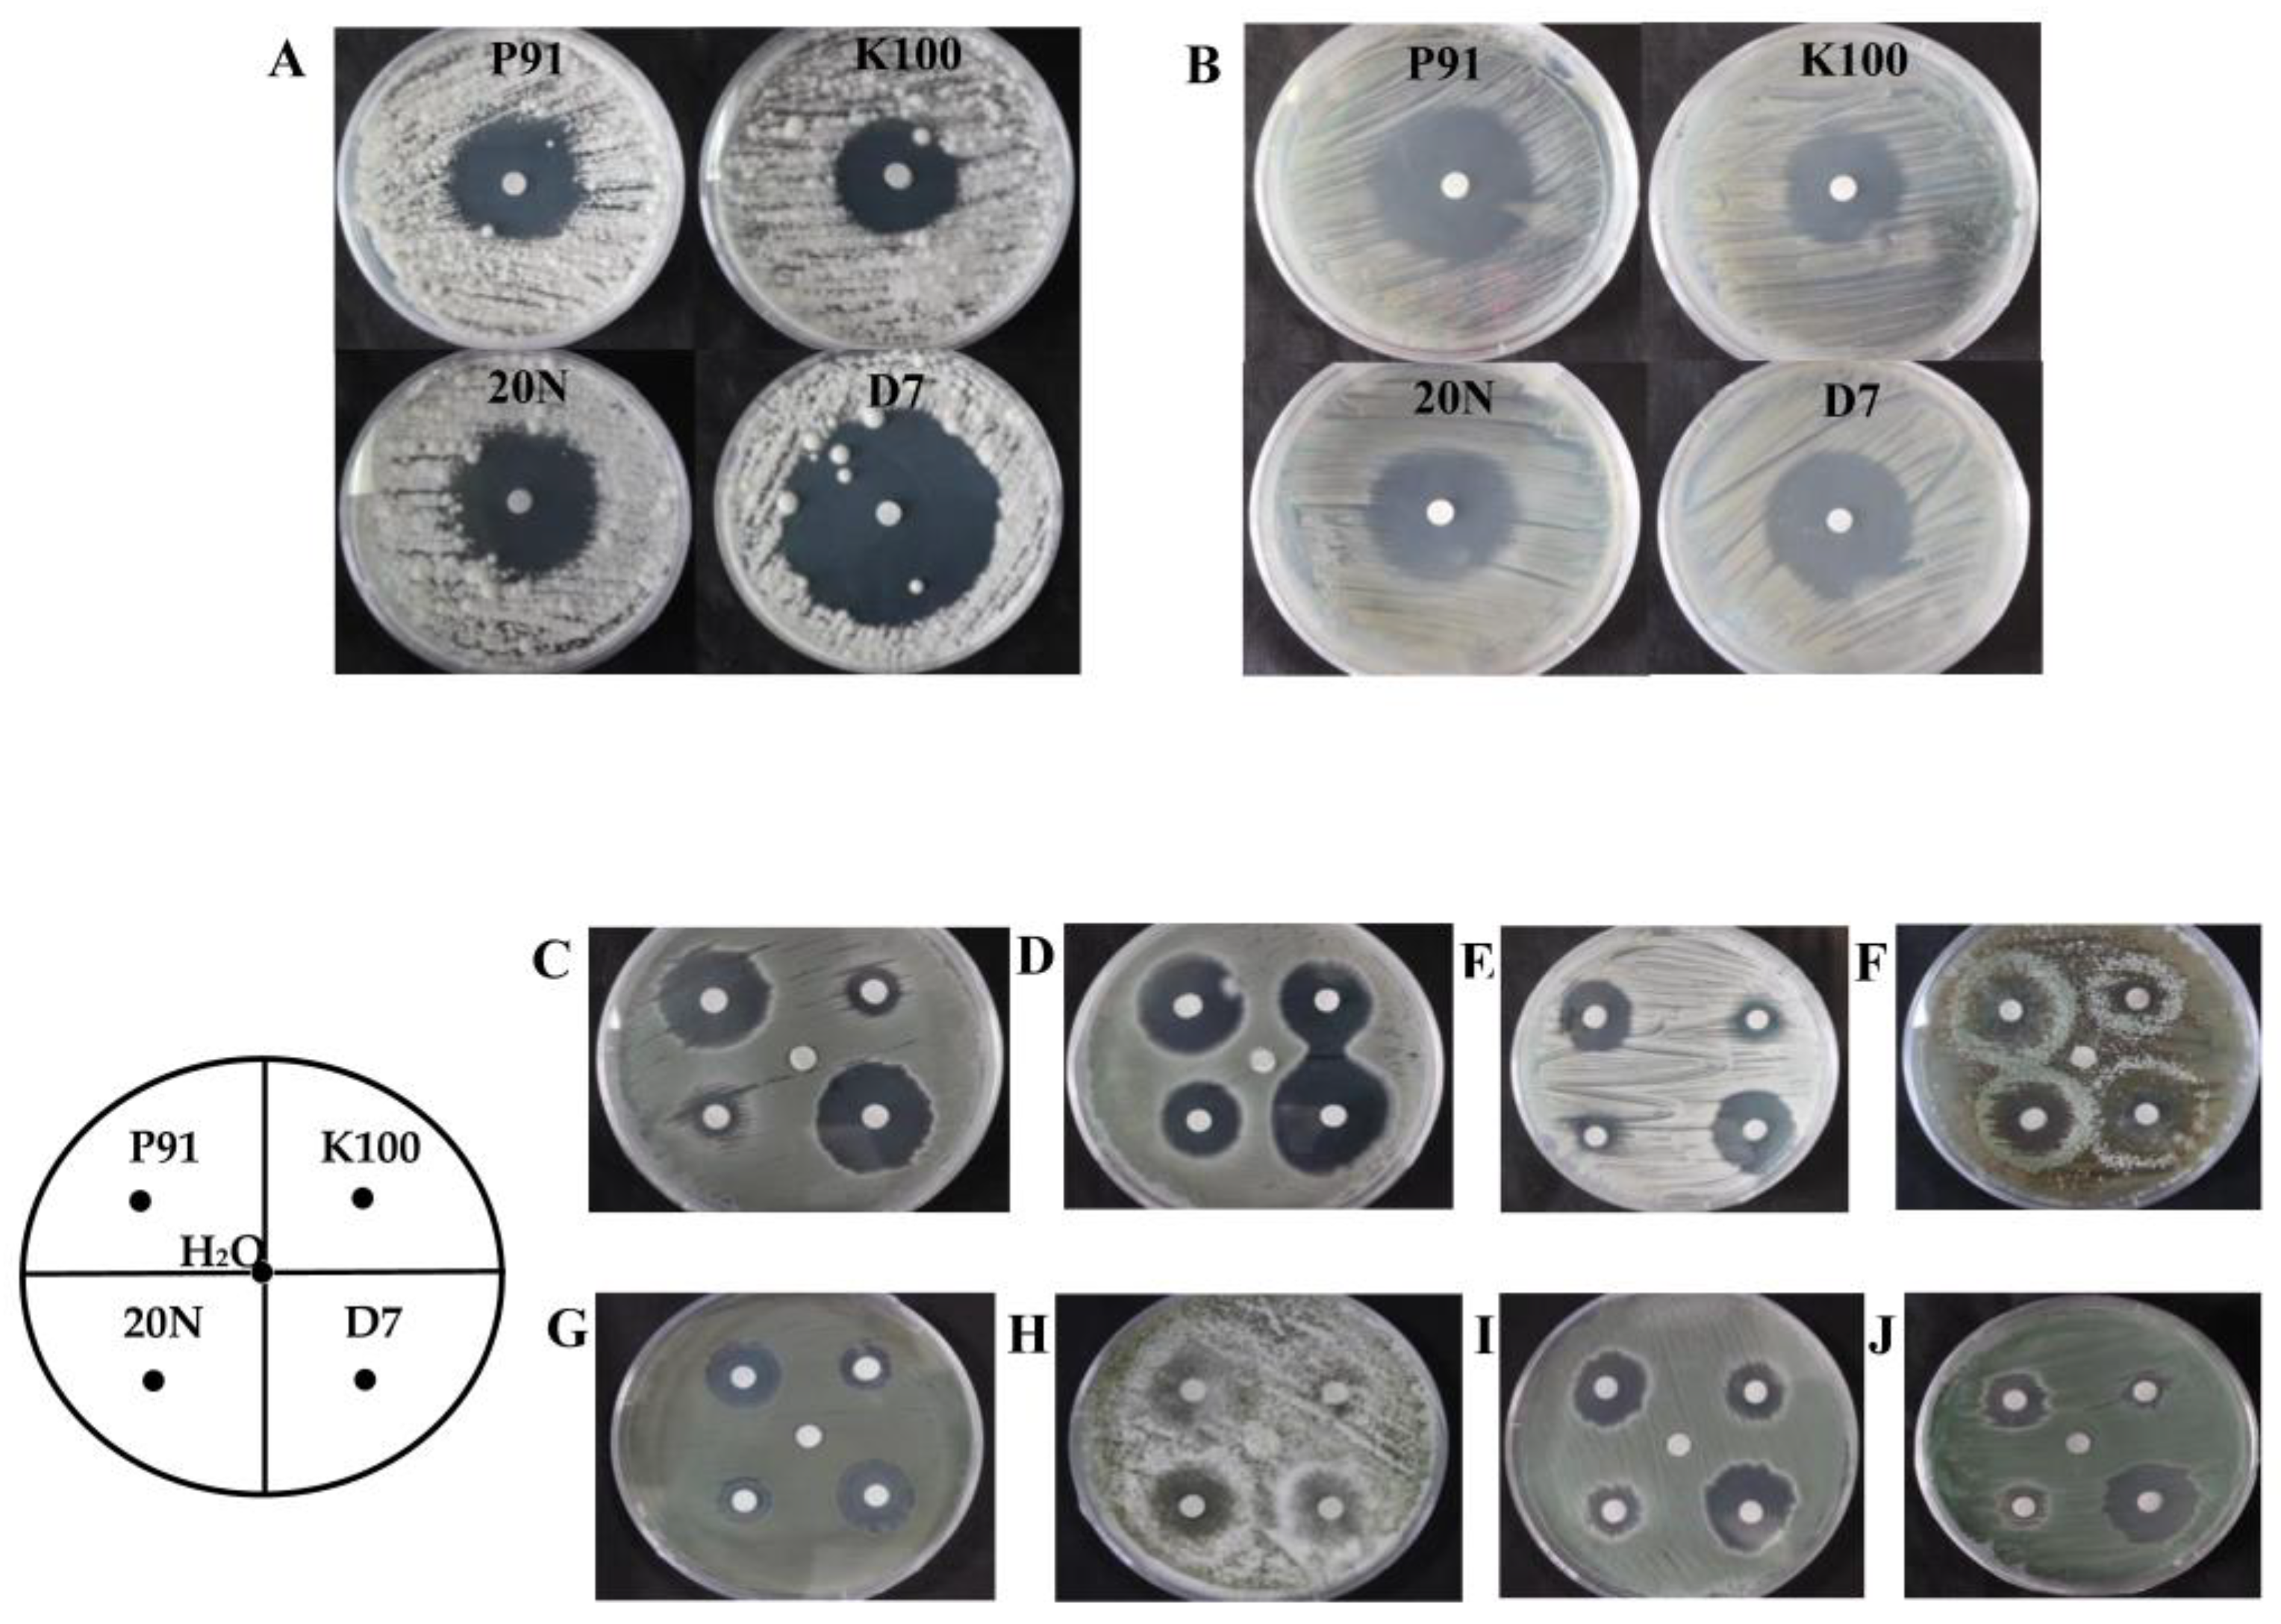
Applsci 09 04129 g005 Applsci 09 04129 g005

Fungal Community Analyses of a Pirogue from the Tang Dynasty in the National Maritime Museum of China
Abstract
1. Introduction
2. Materials and Methods
2.1. Characteristics of the Pirogue
2.2. Sampling
2.3. Isolation and Identification of Fungi
2.4. High-throughput Sequencing Analysis
2.5. Phylogenetic Tree Analysis
2.6. Test the Activity of Lignin-Degrading Enzyme and Cellulase
2.6.1. Lignocellulose-Degrading Enzyme and Cellulase Screening
2.6.2. Cellulase Production and Enzyme Assays
2.7. The Susceptibility of Isolated Fungi to Biocides
3. Results
3.1. Identification of Predominant Fungi by High-Throughput Sequencing
3.2. Identification of Main Fungi by Culture-Dependent Approach
3.3. Phylogenetic Tree Analysis
3.4. Degradation of Lignin and Cellulose by Fungal Isolates
3.5. Sensitivity of Fungal Isolates to Four Biocides
4. Discussion
5. Conclusions
Supplementary Materials
Author Contributions
Funding
Acknowledgments
Conflicts of Interest
References
- Allsopp, D.; Seal, K.J.; Gaylarde, C.C. Introduction to Biodeterioration; Cambridge University Press: Cambridge, UK, 2004; pp. 44–56. [Google Scholar]
- Sterflinger, K.; Piñar, G. Microbial deterioration of cultural heritage and works of art—Tilting at windmills? Appl. Microbiol. Biotechnol. 2013, 97, 9637–9646. [Google Scholar] [CrossRef] [PubMed]
- Piñar, G.; Dalnodar, D.; Voitl, C.; Reschreiter, H.; Sterflinger, K. Biodeterioration risk threatens the 3100 year old staircase of hallstatt (Austria): Possible involvement of halophilic microorganisms. PLoS ONE 2016, 11, e0148279. [Google Scholar] [CrossRef] [PubMed]
- Liu, Z.; Fu, T.; Hu, C.; Shen, D.; Macchioni, N.; Sozzi, L.; Chen, Y.; Liu, J.; Tian, X.; Ge, Q. Microbial community analysis and biodeterioration of waterlogged archaeological wood from the Nanhai No. 1 shipwreck during storage. Sci. Rep. 2018, 8, 7170. [Google Scholar] [CrossRef] [PubMed]
- Grabek-Lejko, D.; Tekiela, A.; Kasprzyk, I. Risk of biodeterioration of cultural heritage objects, stored in the historical and modern repositories in the Regional Museum in Rzeszow (Poland). A case study. Int. Biodeterior. Biodegrad. 2017, 123, 46–55. [Google Scholar] [CrossRef]
- Liu, Z.; Zhang, Y.; Zhang, F.; Hu, C.; Liu, G.; Pan, J. Microbial community analyses of the deteriorated storeroom objects in the Tianjin Museum using culture-independent and culture-dependent approaches. Front. Microbiol. 2018, 9. [Google Scholar] [CrossRef] [PubMed]
- Liu, Z.; Wang, Y.; Pan, X.; Ge, Q.; Ma, Q.; Li, Q.; Fu, T.; Hu, C.; Zhu, X.; Pan, J. Identification of fungal communities associated with the biodeterioration of waterlogged archeological wood in a Han Dynasty tomb in China. Front. Microbiol. 2017, 8, 1633. [Google Scholar] [CrossRef] [PubMed]
- Yin, L.; Jia, Y.; Wang, M.; Yu, H.; Jing, Y.; Hu, C.; Zhang, F.; Sun, M.; Liu, Z.; Chen, Y.; et al. Bacterial and biodeterioration analysis of the waterlogged wooden lacquer plates from the Nanhai No. 1 Shipwreck. Appl. Sci. 2019, 9, 653. [Google Scholar] [CrossRef]
- Chen, Y. The Separation, Identification and Degradation of Lignin of the Bamboo Slips of the ThreeKingdoms Period. Master’s Thesis, Central South University, Changsha, China, 2009. [Google Scholar]
- Kraková, L.; Chovanová, K.; Selim, S.A.; Šimonovičová, A.; Puškarová, A.; Maková, A.; Pangallo, D. A multiphasic approach for investigation of the microbial diversity and its biodegradative abilities in historical paper and parchment documents. Int. Biodeterior. Biodegrad. 2012, 70, 117–125. [Google Scholar] [CrossRef]
- Sterflinger, K. Fungi: Their role in deterioration of cultural heritage. Fungal Biol. Rev. 2010, 24, 47–55. [Google Scholar] [CrossRef]
- Sanmartín, P.; Dearaujo, A.; Vasanthakumar, A. Melding the old with the new: Trends in methods used to identify, monitor, and control microorganisms on cultural heritage materials. Microb. Ecol. 2016, 76, 64–80. [Google Scholar] [CrossRef]
- Möller, E.; Bahnweg, G.; Sandermann, H.; Geiger, H. A simple and efficient protocol for isolation of high molecular weight DNA from filamentous fungi, fruit bodies, and infected plant tissues. Nucleic Acids Res. 1992, 20, 6115. [Google Scholar] [CrossRef] [PubMed]
- Hofstetter, V.; Miadlikowska, J.; Kauff, F.; Lutzoni, F. Phylogenetic comparison of protein-coding versus ribosomal RNA-coding sequence data: A case study of the Lecanoromycetes (Ascomycota). Mol. Phylogenet. Evol. 2007, 44, 412–426. [Google Scholar] [CrossRef] [PubMed]
- White, T.J.; Bruns, T.; Lee, S.; Taylor, J. Amplification and direct sequencing of fungal ribosomal RNA genes for phylogenetics. PCR Protoc. Guide Methods Appl. 1990, 18, 315–322. [Google Scholar]
- Muyzer, G.; De Waal, E.C.; Uitterlinden, A.G. Profiling of complex microbial populations by denaturing gradient gel electrophoresis analysis of polymerase chain reaction-amplified genes coding for 16S rRNA. Appl. Environ. Microbiol. 1993, 59, 695–700. [Google Scholar] [PubMed]
- Caporaso, J.G.; Lauber, C.L.; Walters, W.A.; Berg-Lyons, D.; Lozupone, C.A.; Turnbaugh, P.J.; Fierer, N.; Knight, R. Global patterns of 16S rRNA diversity at a depth of millions of sequences per sample. Proc. Natl. Acad. Sci. USA 2011, 108, 4516–4522. [Google Scholar] [CrossRef] [PubMed]
- Degnan, P.H.; Ochman, H. Illumina-based analysis of microbial community diversity. ISME J. 2012, 6, 183. [Google Scholar] [CrossRef]
- Tamura, K.; Peterson, D.; Peterson, N.; Stecher, G.; Nei, M.; Kumar, S. MEGA5: Molecular evolutionary genetics analysis using maximum likelihood, evolutionary distance, and maximum parsimony methods. Mol. Biol. Evol. 2011, 28, 2731–2739. [Google Scholar] [CrossRef]
- Saitou, N.; Nei, M. The neighbor-joining method: A new method for reconstructing phylogenetic trees. Mol. Biol. Evol. 1987, 4, 406–425. [Google Scholar]
- Tamura, K.; Nei, M. Estimation of the number of nucleotide substitutions in the control region of mitochondrial DNA in humans and chimpanzees. Mol. Biol. Evol. 1993, 10, 512–526. [Google Scholar]
- Viswanath, B.; Chandra, M.S.; Pallavi, H.; Reddy, B.R. Screening and assessment of laccase producing fungi isolated from different environmental samples. Afr. J. Biotechnol. 2008, 7. [Google Scholar] [CrossRef]
- Kasana, R.C.; Salwan, R.; Dhar, H.; Dutt, S.; Gulati, A. A rapid and easy method for the detection of microbial cellulases on agar plates using Gram’s iodine. Curr. Microbiol. 2008, 57, 503–507. [Google Scholar] [CrossRef] [PubMed]
- He, R.; Cai, P.; Wu, G.; Zhang, C.; Zhang, D.; Chen, S. Mutagenesis and evaluation of cellulase properties and cellulose hydrolysis of Talaromyces piceus. World J. Microbiol. Biotechnol. 2015, 31, 1811–1819. [Google Scholar] [CrossRef] [PubMed]
- Irbe, I.; Andersone, I. Wood decay fungi in Latvian buildings including cultural monuments. In Proceedings of the International Conference held by COST Action IE0601, Braga, Portugal, 5–7 November 2008. [Google Scholar]
- Irbe, I.; Karadelev, M.; Andersone, I.; Andersons, B. Biodeterioration of external wooden structures of the Latvian cultural heritage. J. Cult. Herit. 2012, 13, S79–S84. [Google Scholar] [CrossRef]
- Palla, F.; Barresi, G. Biotechnology and Conservation of Cultural Heritage; Springer Nature: Cham, Switzerland, 2017. [Google Scholar]
- Abdel-Kareem, O. Monitoring, controlling and prevention of the fungal deterioration of textile artifacts in the museum of Jordanian heritage. Mediterr. Archaeol. Archaeom. 2010, 10, 85–96. [Google Scholar]
- Pasquarella, C.; Sansebastiano, G.E.; Saccani, E.; Ugolotti, M.; Mariotti, F.; Boccuni, C.; Signorelli, C.; Schianchi, L.F.; Alessandrini, C.; Albertini, R. Proposal for an integrated approach to microbial environmental monitoring in cultural heritage: Experience at the Correggio exhibition in Parma. Aerobiologia 2011, 27, 203–211. [Google Scholar] [CrossRef]
- Skóra, J.; Gutarowska, B.; Pielech-Przybylska, K.; Stępień, Ł.; Pietrzak, K.; Piotrowska, M.; Pietrowski, P. Assessment of microbiological contamination in the work environments of museums, archives and libraries. Aerobiologia 2015, 31, 389–401. [Google Scholar] [CrossRef]
- Abe, K. Assessment of the environmental conditions in a museum storehouse by use of a fungal index. Int. Biodeterior. Biodegrad. 2010, 64, 32–40. [Google Scholar] [CrossRef]
- Kavkler, K.; Gunde-Cimerman, N.; Zalar, P.; Demšar, A. Fungal contamination of textile objects preserved in Slovene museums and religious institutions. Int. Biodeterior. Biodegrad. 2015, 97, 51–59. [Google Scholar] [CrossRef]
- Karbowska-Berent, J.; Górny, R.L.; Strzelczyk, A.B.; Wlazło, A. Airborne and dust borne microorganisms in selected Polish libraries and archives. Build. Environ. 2011, 46, 1872–1879. [Google Scholar] [CrossRef]
- Cabral, J.P. Can we use indoor fungi as bioindicators of indoor air quality? Historical perspectives and open questions. Sci. Total Environ. 2010, 408, 4285–4295. [Google Scholar] [CrossRef]
- Rodríguez, S.F.; Manzano, J.M.M.; Garrido, A.O.; de Tena Pascual, D.; Palacios, I.S.; Garijo, Á.G.; Molina, R.T. Evaluating fungi indoor presence in homes through viable and non-viable sampling. Boletín Micológico 2011, 26, 2–9. [Google Scholar]
- Borrego, S.; Lavin, P.; Perdomo, I.; Gómez de Saravia, S.; Guiamet, P. Determination of indoor air quality in archives and biodeterioration of the documentary heritage. ISRN Microbiol. 2012. [Google Scholar] [CrossRef] [PubMed]
- Harkawy, A.; Górny, R.L.; Ogierman, L.; Wlazlo, A.; Lawniczek-Walczyk, A.; Niesler, A. Bioaerosol assessment in naturally ventilated historical library building with restricted personnel access. Ann. Agric. Environ. Med. 2011, 18, 323–329. [Google Scholar] [PubMed]
- Kalwasinska, A.; Burkowska, A.; Wilk, I. Microbial air contamination in indoor environment of a university library. Ann. Agric. Environ. Med. 2012, 19, 25–29. [Google Scholar] [PubMed]
- Pangallo, D.; Chovanova, K.; Šimonovičová, A.; Ferianc, P. Investigation of microbial community isolated from indoor artworks and air environment: Identification, biodegradative abilities, and DNA typing. Can. J. Microbiol. 2009, 55, 277–287. [Google Scholar] [CrossRef] [PubMed]
- Zielińska-Jankiewicz, K.; Kozajda, A.; Piotrowska, M.; Szadkowska-Stańczyk, I. Microbiological contamination with moulds in work environment in libraries and archive storage facilities. Ann. Agric. Environ. Med. 2008, 15, 71–78. [Google Scholar] [PubMed]
- D’amato, G.; Chatzigeorgiou, G.; Corsico, R.; Gioulekas, D.; Jäger, L.; Jäger, S.; Kontou-Fili, K.; Kouridakis, S.; Liccardi, G.; Meriggi, A. Evaluation of the prevalence of skin prick test positivity to Alternaria and Cladosporium in patients with suspected respiratory allergy: A European multicenter study promoted by the Subcommittee on Aerobiology and Environmental Aspects of Inhalant Allergens of the European Academy of Allergology and Clinical Immunology. Allergy 1997, 52, 711–716. [Google Scholar]
- Flannigan, B.; Samson, R.A.; Miller, J.D. Microorganisms in Home and Indoor Work Environments: Diversity, Health Impacts, Investigation and Control; CRC Press: Boca Raton, FL, USA, 2002. [Google Scholar]

| Fungi | Closest Related Strain | Accession Number | Similarity | Source |
|---|---|---|---|---|
| NKDMZ-1 | Penicillium pimiteouiense | MK551157.1 | 97% | hull |
| NKDMZ-2 | Penicillium sumatrense | KT310939.1 | 89% | hull |
| NKDMZ-3 | Penicillium sumatrense | KT310939.1 | 89% | hull |
| NKDMZ-4 | Cladosporium cladosporioides | HQ148094.1 | 98% | hull |
| NKDMZ-5 | Talaromyces pinophilus | KY979508.1 | 99% | hull |
| NKDMZ-6 | Talaromyces variabilis | KU216713.1 | 99% | hull |
| NKDMZ-9 | Cladosporium cladosporioides | HM776418.1 | 98% | air |
| NKDMZ-10 | Cladosporium cladosporioides | KX815294.1 | 97% | air |
| NKDMZ-11 | Cladosporium cladosporioides | KY114882.1 | 98% | air |
| NKDMZ-12 | Cladosporium cladosporioides | KX815294.1 | 96% | air |
| NKDMZ-13 | Cladosporium cladosporioides | KX815294.1 | 96% | air |
| NKDMZ-14 | Cladosporium uredinicola | JN088229.1 | 84% | air |
| NKDMZ-15 | Penicillium sumatrense | KT310939.1 | 89% | air |
| NKDMZ-16 | Trichoderma afroharzianum | KX357849.1 | 97% | air |
© 2019 by the authors. Licensee MDPI, Basel, Switzerland. This article is an open access article distributed under the terms and conditions of the Creative Commons Attribution (CC BY) license (http://creativecommons.org/licenses/by/4.0/).
Share and Cite
Zhang, F.; Li, L.; Sun, M.; Hu, C.; Zhang, Z.; Liu, Z.; Shao, H.; Xi, G.; Pan, J. Fungal Community Analyses of a Pirogue from the Tang Dynasty in the National Maritime Museum of China. Appl. Sci. 2019, 9, 4129. https://doi.org/10.3390/app9194129
Zhang F, Li L, Sun M, Hu C, Zhang Z, Liu Z, Shao H, Xi G, Pan J. Fungal Community Analyses of a Pirogue from the Tang Dynasty in the National Maritime Museum of China. Applied Sciences. 2019; 9(19):4129. https://doi.org/10.3390/app9194129
Chicago/Turabian StyleZhang, Fengyu, Lin Li, Mingliang Sun, Cuiting Hu, Zhiguo Zhang, Zijun Liu, Hongfei Shao, Guanglan Xi, and Jiao Pan. 2019. "Fungal Community Analyses of a Pirogue from the Tang Dynasty in the National Maritime Museum of China" Applied Sciences 9, no. 19: 4129. https://doi.org/10.3390/app9194129
APA StyleZhang, F., Li, L., Sun, M., Hu, C., Zhang, Z., Liu, Z., Shao, H., Xi, G., & Pan, J. (2019). Fungal Community Analyses of a Pirogue from the Tang Dynasty in the National Maritime Museum of China. Applied Sciences, 9(19), 4129. https://doi.org/10.3390/app9194129
